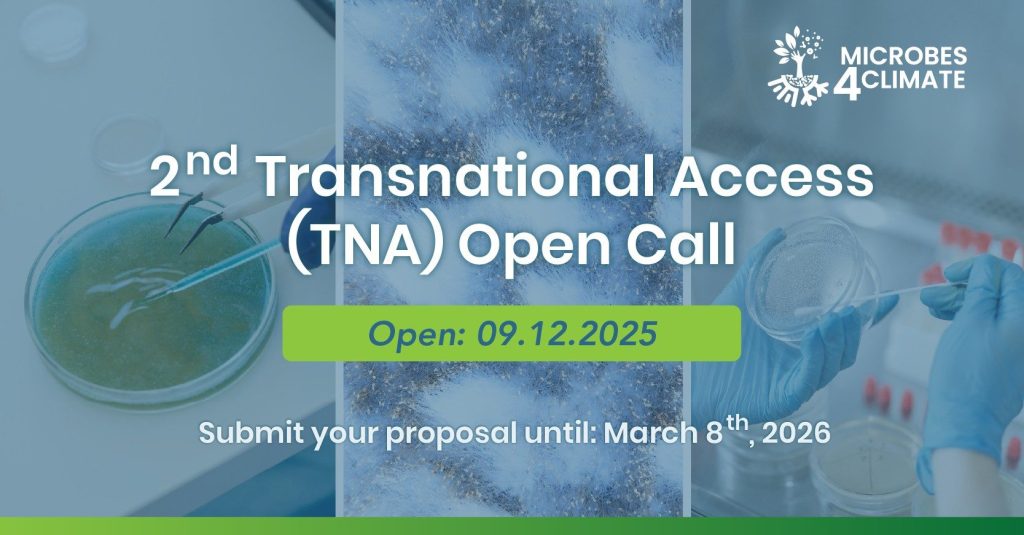

Tags :

AnaEE-ERIC’s 2nd International Science Conference brings together researchers and policymakers to tackle critical ecosystem challenges through 7 thematic sessions featuring distinguished speakers listed below. The conference spans experimental approaches to global change ecology, forest and agricultural resilience, aquatic-terrestrial interactions, and innovative data integration methods.
List of AnaEE member universities/institutes
Our network brings together leading research institutions, universities, and organizations from across Europe, united by a shared commitment to advancing ecosystem science. Each member contributes unique expertise, facilities, and perspectives, creating a powerful collective capability that no single institution could achieve alone.
What is TNA?
Transnational Access (TNA) is a funding program that lets researchers from one country use specialized research facilities, equipment, or resources located in another country – usually for free or at reduced cost.
How it works: Think of it like a library card system, but for expensive scientific equipment. A researcher in Spain might need to use a specialized telescope in Chile, or a particle accelerator in Switzerland, or a rare biological collection in Germany. TNA programs cover the costs so researchers can access these facilities they couldn’t otherwise afford.
Key points:
Example: A marine biologist in Poland wants to study deep-sea creatures but doesn’t have access to a research vessel. Through TNA, they could apply to use a marine research station in Norway, with costs covered by the program.
It’s essentially about democratizing access to world-class research infrastructure and promoting international scientific collaboration. Several of our projects offer TNA funding, explore them in the links below.
